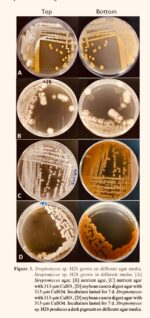
Meycauayan River microbes ‘eat’ plastic, may hold cancer cure Meycauayan River microbes ‘eat’ plastic, may hold cancer cure

Metro Pacific Tollways Corp. (MPTC) is widening its KaBiyahe Rebate Program to more Luzon expressways, aiming to cushion transport operators from rising fuel costs and steady the movement of essential goods.
MPTC said the expanded rollout—done with joint-venture partners Bases Conversion and Development Authority (BCDA) for SCTEX and Philippine Reclamation Authority (PRA) for CAVITEX—answers the government’s call for temporary financial relief across the transport sector.
The two-month program runs from March 23 to May 22, 2026, covering all trips along NLEX, SCTEX, and CAVITEX, including the R1 Expressway and its extension. Rebates will effectively bring toll rates back to pre-adjustment levels.
Qualified beneficiaries include Class 2 public utility buses, modernized jeepneys, and Class 3 vehicles.
To avail, Class 3 vehicles must be active Easytrip subscribers in good standing, maintain sufficient load, and not be enrolled in other rebate or discount schemes such as the Toll Exemption for Agricultural Trucks.
Public utility buses and modernized jeepneys, meanwhile, are required to enroll in the KaBiyahe Program by submitting documents via email.
Applicants must be accredited operators registered with the Land Transportation Franchising and Regulatory Board, maintain an Easytrip prepaid account in good standing, and not be part of other toll discount programs. Enrollment runs from March 23 to April 5.
MPTC said operators who incur traffic violations during the program period will be disqualified from receiving rebates.
The company added that Class 1 public utility jeepneys on northern routes will continue to benefit from the PASSADA Program, while the Abante Program will be reactivated on CAVITEX for two months, granting rebates equivalent to the latest toll increase.